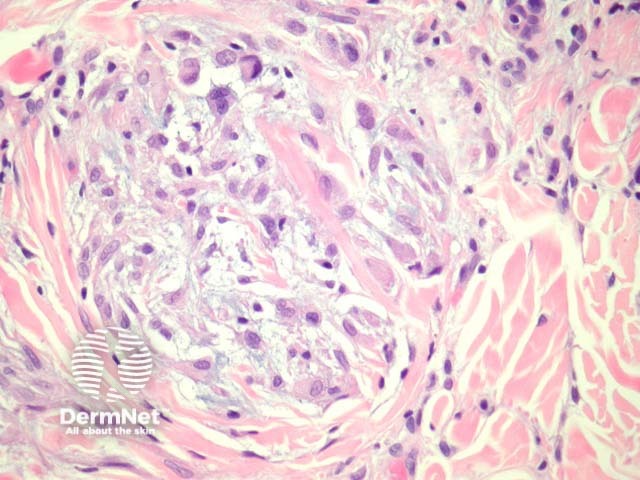
Figure 3

Main menu
Common skin conditions
NEWS
Join DermNet PRO
Read more
Quick links
Author: Assoc Prof Patrick Emanuel, Dermatopathologist, Auckland, New Zealand, 2013.
Neurothekeoma is a benign cutaneous neoplasm. It is histologically divided into myxoid and cellular types, which may actually be two completely different entities. The myxoid variant of neurothekeoma is of neural origin. The cellular variant, however, is of questionable origin.
The cellular subtype of neurothekeoma is composed of a circumscribed proliferation of spindled and epithelioid cells in lobules and fascicles. Sclerotic collagen is common between the lobules (figures 1, 2, 3). Intermixed giant cells may be seen.
The cells are embedded within a myxoid stroma. Like the cellular variant of neurothekeoma, the myxoid neurothekeoma displays a lobulated growth pattern (figure 4, 5).

Figure 1

Figure 2
Figure 3

Figure 4

Figure 5
Cellular neurothekeoma — NKI/C3, PGP9.5, S100 A6 are usually positive. S100 is negative (in contrast to the myxoid type).
Myxoid neurothekeoma — S100 protein and glial fibrillary acidic protein (GFAP) positivity.
Schwannoma — The myxoid type of neurothekeoma is thought to be of neural origin and as such may resemble schwannoma. Myxoid neurothekeoma lacks Verocay bodies and the Antoni A, B arrangement seen in schwannoma.
Melanocytic tumour — The solid nested growth pattern of cellular neurothekeoma may resemble a melanocytic tumour. Melanocytic lesions are almost invariably S100 positive while cellular neurothekeoma is S100 negative.